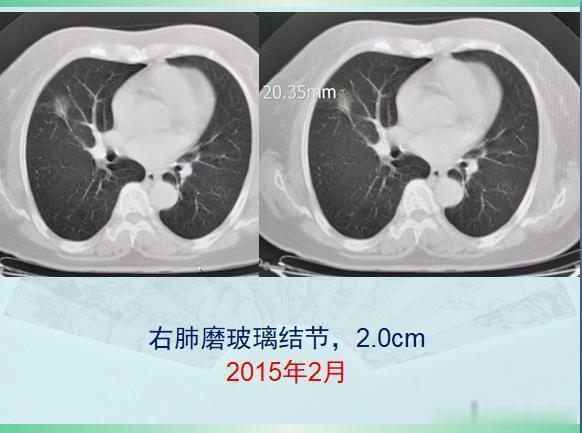
原发灶|两个肺癌病人都拖了2年才治疗,一个治愈,一个扩散了

原发灶|两个肺癌病人都拖了2年才治疗,一个治愈,一个扩散了
今天遇到的两位肺癌病人,让人很是感慨:癌症病人的运气,太重要!第一位,乳腺癌手术后2年又查出肺癌,拖了两年才手术,很成功!这是一位71岁的老太太,乳腺癌手术后定期体检,又发现右肺磨玻璃结节灶,大小2.0厘米:
【 原发灶|两个肺癌病人都拖了2年才治疗,一个治愈,一个扩散了】
文章插图
很多人的运气不够好,一辈子会得两次癌症,甚至有极少数人会多次患癌。这位老太太会不会是肺癌呢?病人拒绝了进一步检查,选择随访观察,走一步看一步吧,就这样随访了两年,每年做一次肺CT:

文章插图
CT显示,这个混合磨玻璃结节边界清晰,以一种很缓慢的速度在增长,白色的实性成分在增加,并且开始出现胸膜牵拉,这提示典型的肺腺癌征象了。在前面的《豪大夫讲肺结节》系列文章种,又一个肺腺癌的知识点我们反复提起过:边界清晰的混合磨玻璃结节,伴有胸膜牵拉,诊断肺腺癌准确率极高!CT图片就可以诊断肺癌了,甚至不需要穿刺病理。并且我们也提过,伴有胸膜牵拉的肺腺癌,癌细胞容易沿着胸膜的脉管系统(主要是淋巴)发生转移,很多人会因此失去手术机会,有些肿瘤甚至还不到2厘米。这个病灶不能拖了!后来经过商议,老人去胸外科做了胸腔镜微创手术切除,病理是浸润性肺腺癌(贴壁生长为主,伴有腺泡和乳头状生长,属于中高分化),胸膜尚未受累,清扫了8枚淋巴结也未发现癌细胞转移!今年已经两年了,今天复查没有复发,恢复很好!

文章插图
这位病人很不幸,得过乳腺癌,又得了肺癌,但她又很幸运,两次癌症都做了根治手术,尤其这个肺腺癌,中间拖了两年都没有转移,癌细胞相对很温柔!假如所有的癌症病人身上,都是这种慢吞吞的癌细胞就好了!很可惜,不是!第二位,胸痛2年,一直拖着这是一位69岁的男病人,常年吸烟,每天一包,两年前开始偶尔胸痛,能忍受,没有咳嗽咳痰咳血等其他症状,也就没当回事。最近一个月加重了,晚上需要吃止疼片才能顺利入睡,就过来做了肺CT,结果发现左肺长了一个像土豆一样圆滚滚的肿块:

文章插图
增强CT显示肿块轻度不均匀强化,同时还发现了纵隔淋巴结肿大,符合肺癌,而且他已经没有手术机会了。同样是拖了两年,这位病人的运气就没有第一位老太太那么好!

文章插图
后来老人做了经皮肺穿刺,病理是小细胞肺癌。实际上CT图像也提示小细胞肺癌的诊断:1.原发灶比较光滑,像土豆一样,可以有浅分叶,血供不丰富所以轻度强化;2.小细胞肺癌对血管破坏比鳞癌轻,很少发生大片坏死,所以空洞少见;3.小细胞肺癌转移早,原发灶较小时就常见肺门及纵隔淋巴结多发转移,从而失去手术机会;4.与吸烟关系密切。不过幸运的是,这位老人的肺癌对化疗很敏感,做了两个周期的化疗(依托泊苷+奈达铂)后复查,病灶明显缩小,纵隔淋巴结也萎缩了:

文章插图
- 航线|确诊旅客12例!这两个飞上海国际航班被熔断
- 妈妈和我都喜欢逛菜市场|花40块钱买了两个“节节香”的猪尾巴,腰酸背痛多吃点
- 传播|国家卫健委:两个因素导致近期国内多起聚集性疫情隐匿传播时间较长
- 病毒|国家卫健委:两个因素导致近期国内多起聚集性疫情隐匿传播时间较长
- 病毒|国家卫健委:两个因素致近期国内多起聚集性疫情隐匿传播时间较长
- 小习惯|10 个饭后小习惯,有两个真不建议你做!
- 鲁南制药|省医药行业协会到鲁南制药调研,现场颁了两个奖
- 便秘|每天按揉5分钟这两个穴位,从此和便秘说“拜拜”比开塞露还灵
- 血虚|血虚、气虚、睡不好,怎么补?中医补治结合,把握这两个规律,你就抓住了养生的精髓!
- 原发性肿瘤|年轻女孩,双肺长满疙瘩,一查是卵巢癌,为什么肺这么容易被转移
